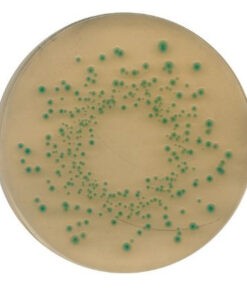
TBX (Tryptone Bile X-glucuronide) agar Merck

Chưa phân loại
0 ₫
Hóa chất thí nghiệm
0 ₫
Hóa chất thí nghiệm
0 ₫
Hóa chất thí nghiệm
0 ₫
Hóa chất thí nghiệm
0 ₫
Hóa chất thí nghiệm
TCBS agar for the isolation and selective cultivation of Vibrio cholera
0 ₫
Hóa chất thí nghiệm
0 ₫
Hóa chất thí nghiệm
0 ₫